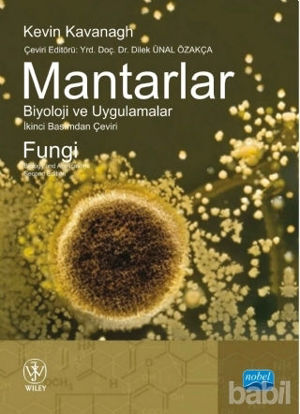
Picture of Mantarlar Biyoloji ve Uygulamalar

You have no items in your shopping cart.
- Çocuk Kitapları (17209)
- Bilmece, Bulmaca (898)
- Çıkartmalı Kitaplar (490)
- Diğer (1978)
- Okul Öncesi Çocuk Kitapları (1090)
- Roman-Öykü (4763)
- Çizgi Roman (254)
- Hikayeler (6312)
- Referans Kitaplar (271)
- Boyama Kitapları (631)
- Hobi-Müzik (256)
- Oyun Kitapları (309)
- Okul Öncesi Şekilli Kitaplar (115)
- Zeka Gelişimi (426)
- Masallar (1632)
- Şiir Kitapları (167)
- Din Eğitimi (438)
- Dünya Klasikleri (257)
- Türk Klasikleri (12)
- Bilimsel Kitaplar (604)
- Yapbozlu Kitaplar (7)
- Hobi (1304)
- Edebiyat (39354)
- Çizgi Roman (1607)
- Şiir (6091)
- Deneme (2985)
- Araştırma-İnceleme-Referans (1329)
- Türk Edebiyatı (6239)
- Biyografi-Otobiyografi (1398)
- Senaryo (806)
- Roman (11412)
- İngiliz Edebiyatı (453)
- Divan Edebiyatı - Halk Edebiyatı (341)
- Bilimkurgu (346)
- Alman Edebiyatı (258)
- Tarihsel Romanlar (1036)
- Anı - Mektup - Günlük (1877)
- Aksiyon - Macera (426)
- Öykü (3575)
- Polisiye (816)
- Derleme (110)
- Eleştiri, İnceleme, Kuram (556)
- Amerikan Edebiyatı (639)
- İtalyan Edebiyatı (92)
- Diğer Ülke Edebiyatları (535)
- Antoloji (227)
- Rus Edebiyatı (465)
- Aşk (645)
- Korku-Gerilim (385)
- Anlatı (466)
- Politik Kurgu (79)
- Fransız Edebiyatı (431)
- Kürt Edebiyatı (514)
- Latin Edebiyatı (67)
- Mizah (456)
- Dil Bilim (169)
- Fantastik (748)
- Efsane-Destan (195)
- Ortadoğu - Arap Edebiyatı (111)
- Klasikler (673)
- Uzakdoğu Edebiyatı (55)
- Oyun (273)
- Karikatür (121)
- İskandinav Edebiyatı (20)
- Periyodik Yayınlar (13)
- İspanyol Edebiyatı (74)
- Gençlik Edebiyatı (454)
- Söyleşi (123)
- Seyahatname (45)
- Genel Konular (8814)
- Sanat (2164)
- Felsefe (3610)
- Müzik (559)
- Akademik (5826)
- İnsan ve Toplum (5295)
- Ekonomi (3545)
- İşletme, Muhasebe, Maliye (908)
- Halkla İlişkiler, İnsan Kaynakları (554)
- İş Dünyası (764)
- Türkiye Ekonomisi (363)
- Araştırma-İnceleme-Kuram (610)
- Dünya Ekonomisi (313)
- Borsa - Finans (281)
- Küreselleşme (33)
- Yönetim (443)
- Diğer (593)
- Referans Kitaplar (50)
- Pazarlama, Satış, Reklam (236)
- E-Ticaret (38)
- Hukuk (2703)
- Bilim - Mühendislik (1570)
- Popüler Bilim (380)
- Doğa Bilimleri (79)
- Tıp Bilimleri (243)
- Bilim Tarihi (121)
- Diğer (376)
- Matematik - Geometri (98)
- Nükleer Enerji Mühendisliği (2)
- Bilgisayar Mühendisliği (7)
- İnşaat Mühendisliği (28)
- Elektrik-Elektronik Mühendisliği (19)
- Makine Mühendisliği (19)
- Astronomi - Fizik (34)
- Mimarlık (48)
- Kimya (10)
- Sosyal Bilimler (84)
- Psikoloji (1472)
- Periyodik Yayınlar (2054)
- Gezi ve Rehber Kitapları (835)
- Yemek Kitapları (357)
- Bilgisayar (558)
- Microsoft Office (59)
- Bilgisayar Öğrenimi (20)
- Diğer (92)
- Programlama (234)
- İnternet ve İnternet Kültürü (49)
- İşletim Sistemleri (21)
- Grafik ve Tasarım (88)
- Web Geliştirme ve Tasarım (84)
- Veritabanı - Database (16)
- Ağ - Networking (17)
- Bilgisayar Teknolojisi (36)
- Donanım - Hardware (2)
- Güvenlik - Security (10)
Categories
- Çocuk Kitapları (17209)
- Bilmece, Bulmaca (898)
- Çıkartmalı Kitaplar (490)
- Diğer (1978)
- Okul Öncesi Çocuk Kitapları (1090)
- Roman-Öykü (4763)
- Çizgi Roman (254)
- Hikayeler (6312)
- Referans Kitaplar (271)
- Boyama Kitapları (631)
- Hobi-Müzik (256)
- Oyun Kitapları (309)
- Okul Öncesi Şekilli Kitaplar (115)
- Zeka Gelişimi (426)
- Masallar (1632)
- Şiir Kitapları (167)
- Din Eğitimi (438)
- Dünya Klasikleri (257)
- Türk Klasikleri (12)
- Bilimsel Kitaplar (604)
- Yapbozlu Kitaplar (7)
- Hobi (1304)
- Edebiyat (39354)
- Çizgi Roman (1607)
- Şiir (6091)
- Deneme (2985)
- Araştırma-İnceleme-Referans (1329)
- Türk Edebiyatı (6239)
- Biyografi-Otobiyografi (1398)
- Senaryo (806)
- Roman (11412)
- İngiliz Edebiyatı (453)
- Divan Edebiyatı - Halk Edebiyatı (341)
- Bilimkurgu (346)
- Alman Edebiyatı (258)
- Tarihsel Romanlar (1036)
- Anı - Mektup - Günlük (1877)
- Aksiyon - Macera (426)
- Öykü (3575)
- Polisiye (816)
- Derleme (110)
- Eleştiri, İnceleme, Kuram (556)
- Amerikan Edebiyatı (639)
- İtalyan Edebiyatı (92)
- Diğer Ülke Edebiyatları (535)
- Antoloji (227)
- Rus Edebiyatı (465)
- Aşk (645)
- Korku-Gerilim (385)
- Anlatı (466)
- Politik Kurgu (79)
- Fransız Edebiyatı (431)
- Kürt Edebiyatı (514)
- Latin Edebiyatı (67)
- Mizah (456)
- Dil Bilim (169)
- Fantastik (748)
- Efsane-Destan (195)
- Ortadoğu - Arap Edebiyatı (111)
- Klasikler (673)
- Uzakdoğu Edebiyatı (55)
- Oyun (273)
- Karikatür (121)
- İskandinav Edebiyatı (20)
- Periyodik Yayınlar (13)
- İspanyol Edebiyatı (74)
- Gençlik Edebiyatı (454)
- Söyleşi (123)
- Seyahatname (45)
- Genel Konular (8814)
- Sanat (2164)
- Tarih (8564)
- Politika Siyaset (6029)
- Dünya Siyaseti ve Politikası (1401)
- Uluslararası İlişkiler, Dış Politika (885)
- Diğer (1852)
- Siyaset Bilimi (602)
- Avrupa Birliği (281)
- Azınlıklar, Etnik Sorunlar (740)
- Genel Politika, Siyaset Bilim, Siyaset Tarihi (1173)
- İslam, Ortadoğu (265)
- Kurumlar, Örgütler (369)
- Derin Siyaset, Komplo Teorileri (270)
- Sol Hareketler (568)
- Türkiye Siyaseti ve Politikası (1093)
- Araştırma-İnceleme (987)
- Politik Akımlar - Hareketler (1144)
- Güncel Siyaset (99)
- İslam (9447)
- İslam ve Günümüz İslam Düşüncesi (643)
- Tasavvuf - Mezhepler - Tarikatlar (1753)
- Diğer (3219)
- İslam Tarihi (595)
- Kuran ve Kuran Üzerine (1643)
- Araştırma-İnceleme (1538)
- Biyografi - Otobiyografi (605)
- Edebiyat - Roman (665)
- İslam Eğitimi (910)
- Aile ve Çocuk (3)
- İslam Hukuku (131)
- Alevilik-Bektaşilik (292)
- Meal-Tefsir-Hadis (375)
- İman Esasları (24)
- Felsefe (3610)
- Müzik (559)
- Eğitim (5735)
- Akademik (5826)
- Sosyoloji (2605)
- İnsan ve Toplum (5295)
- Ekonomi (3545)
- İşletme, Muhasebe, Maliye (908)
- Halkla İlişkiler, İnsan Kaynakları (554)
- İş Dünyası (764)
- Türkiye Ekonomisi (363)
- Araştırma-İnceleme-Kuram (610)
- Dünya Ekonomisi (313)
- Borsa - Finans (281)
- Küreselleşme (33)
- Yönetim (443)
- Diğer (593)
- Referans Kitaplar (50)
- Pazarlama, Satış, Reklam (236)
- E-Ticaret (38)
- Hukuk (2703)
- İnanç Kitapları - Mitolojiler (1168)
- Bilim - Mühendislik (1570)
- Popüler Bilim (380)
- Doğa Bilimleri (79)
- Tıp Bilimleri (243)
- Bilim Tarihi (121)
- Diğer (376)
- Matematik - Geometri (98)
- Nükleer Enerji Mühendisliği (2)
- Bilgisayar Mühendisliği (7)
- İnşaat Mühendisliği (28)
- Elektrik-Elektronik Mühendisliği (19)
- Makine Mühendisliği (19)
- Astronomi - Fizik (34)
- Mimarlık (48)
- Kimya (10)
- Sosyal Bilimler (84)
- Psikoloji (1472)
- Yabancı Dilde Kitaplar (2240)
- Sağlık (1399)
- Periyodik Yayınlar (2054)
- Gezi ve Rehber Kitapları (835)
- Yemek Kitapları (357)
- Bilgisayar (558)
- Microsoft Office (59)
- Bilgisayar Öğrenimi (20)
- Diğer (92)
- Programlama (234)
- İnternet ve İnternet Kültürü (49)
- İşletim Sistemleri (21)
- Grafik ve Tasarım (88)
- Web Geliştirme ve Tasarım (84)
- Veritabanı - Database (16)
- Ağ - Networking (17)
- Bilgisayar Teknolojisi (36)
- Donanım - Hardware (2)
- Güvenlik - Security (10)
- Genel (0)
- Güncellenecek (0)
- GÜNCELLENECEK (0)
- Kırtasiye (0)
- Hizmet (7)
- Oyun - Oyuncak (0)
- Electronics (9)
- Apparel (10)
- Digital downloads (3)
- Books (3)
- Jewelry (3)
- Gift Cards (3)
- Home /
- Akademik
Price
-
Manufacturer
Writers
Cep boy olup olmadığı bilgisi
- False 5826
Baskı sayısı
En bilgisi (cm)
Basım şehri adı
Boy bilgisi (cm)
Basım tarihi yıl bilgisi
- 2019 689
- 2020 593
- 2014 415
- 2012 403
- 2013 389
- 2018 380
- 2011 326
- 2010 274
- 2015 266
- 2017 219
- 2016 194
- 2007 161
- 2009 161
- 2006 128
- 2008 106
- 2005 101
- 2004 82
- 2003 67
- 2001 33
- 2002 28
- 1999 23
- 2000 23
- 2021 21
- 1997 17
- 1993 14
- 1998 11
- 1990 10
- 1991 10
- 1996 9
- 1995 9
- 1989 9
- 1994 7
- 1984 6
- 1986 5
- 1992 4
- 1988 4
- 1987 4
Ağırlık bilgisi (gram)
- 200,00 55
- 300,00 47
- 240,00 38
- 160,00 37
- 400,00 37
- 176,00 36
- 192,00 35
- 232,00 35
- 280,00 34
- 208,00 31
- 320,00 31
- 288,00 29
- 272,00 29
- 184,00 27
- 360,00 27
- 416,00 26
- 230,00 26
- 144,00 26
- 202,00 25
- 296,00 24
- 464,00 24
- 384,00 24
- 336,00 24
- 120,00 23
- 480,00 23
- 220,00 23
- 312,00 22
- 500,00 22
- 166,00 22
- 248,00 22
- 224,00 22
- 168,00 21
- 368,00 21
- 216,00 20
- 600,00 20
- 238,00 20
- 142,00 20
- 282,00 20
- 100,00 19
- 260,00 19
- 264,00 19
- 268,00 18
- 136,00 18
- 128,00 18
- 284,00 18
- 212,00 18
- 302,00 18
- 256,00 18
- 392,00 18
- 310,00 18
- 352,00 17
- 274,00 17
- 344,00 17
- 314,00 17
- 512,00 17
- 456,00 17
- 358,00 17
- 250,00 17
- 290,00 17
- 472,00 16
- 292,00 16
- 174,00 16
- 328,00 16
- 334,00 16
- 134,00 16
- 244,00 16
- 340,00 16
- 242,00 15
- 194,00 15
- 318,00 15
- 376,00 15
- 112,00 15
- 266,00 15
- 528,00 15
- 235,00 15
- 222,00 15
- 350,00 15
- 262,00 15
- 372,00 15
- 448,00 15
- 196,00 15
- 440,00 15
- 190,00 15
- 333,00 14
- 158,00 14
- 180,00 14
- 261,00 14
- 162,00 14
- 294,00 14
- 150,00 14
- 432,00 14
- 152,00 14
- 326,00 14
- 348,00 14
- 156,00 14
- 324,00 14
- 258,00 14
- 380,00 14
- 148,00 13
- 408,00 13
- 370,00 13
- 209,00 13
- 306,00 13
- 338,00 13
- 170,00 13
- 366,00 13
- 332,00 13
- 252,00 13
- 298,00 13
- 206,00 13
- 278,00 13
- 96,00 13
- 414,00 13
- 214,00 13
- 110,00 13
- 396,00 13
- 70,00 12
- 204,00 12
- 255,00 12
- 304,00 12
- 1000,00 12
- 301,00 12
- 186,00 12
- 234,00 12
- 412,00 12
- 520,00 12
- 454,00 12
- 322,00 12
- 410,00 12
- 330,00 12
- 450,00 12
- 178,00 12
- 218,00 12
- 140,00 12
- 188,00 12
- 420,00 12
- 130,00 12
- 444,00 12
- 362,00 12
- 201,00 12
- 335,00 12
- 283,00 11
- 592,00 11
- 172,00 11
- 185,00 11
- 522,00 11
- 213,00 11
- 253,00 11
- 544,00 11
- 468,00 11
- 323,00 11
- 135,00 11
- 390,00 11
- 236,00 11
- 124,00 11
- 496,00 11
- 354,00 11
- 640,00 11
- 254,00 11
- 228,00 11
- 182,00 11
- 388,00 11
- 249,00 11
- 210,00 11
- 436,00 11
- 226,00 10
- 407,00 10
- 183,00 10
- 364,00 10
- 424,00 10
- 576,00 10
- 374,00 10
- 536,00 10
- 195,00 10
- 173,00 10
- 225,00 10
- 560,00 10
- 552,00 10
- 308,00 10
- 246,00 10
- 315,00 10
- 118,00 10
- 132,00 10
- 486,00 10
- 131,00 10
- 550,00 9
- 430,00 9
- 313,00 9
- 287,00 9
- 341,00 9
- 452,00 9
- 405,00 9
- 510,00 9
- 518,00 9
- 431,00 9
- 542,00 9
- 422,00 9
- 198,00 9
- 215,00 9
- 275,00 9
- 116,00 9
- 404,00 9
- 485,00 9
- 442,00 9
- 146,00 9
- 104,00 9
- 327,00 8
- 402,00 8
- 434,00 8
- 316,00 8
- 439,00 8
- 241,00 8
- 263,00 8
- 307,00 8
- 297,00 8
- 227,00 8
- 403,00 8
- 141,00 8
- 455,00 8
- 598,00 8
- 449,00 8
- 558,00 8
- 394,00 8
- 504,00 8
- 286,00 8
- 389,00 8
- 122,00 8
- 437,00 8
- 247,00 8
- 270,00 8
- 199,00 8
- 133,00 8
- 462,00 8
- 535,00 8
- 466,00 8
- 187,00 8
- 147,00 8
- 163,00 8
- 245,00 8
- 92,00 8
- 492,00 8
- 231,00 8
- 126,00 8
- 325,00 8
- 495,00 8
- 656,00 8
- 406,00 8
- 303,00 8
- 337,00 8
- 159,00 8
- 175,00 8
- 530,00 8
- 494,00 8
- 458,00 8
- 516,00 8
- 84,00 7
- 638,00 7
- 87,00 7
- 690,00 7
- 157,00 7
- 704,00 7
- 643,00 7
- 476,00 7
- 346,00 7
- 239,00 7
- 98,00 7
- 164,00 7
- 171,00 7
- 385,00 7
- 608,00 7
- 105,00 7
- 551,00 7
- 129,00 7
- 508,00 7
- 106,00 7
- 80,00 7
- 688,00 7
- 488,00 7
- 446,00 7
- 393,00 7
- 291,00 7
- 271,00 7
- 547,00 7
- 470,00 7
- 670,00 7
- 594,00 7
- 568,00 7
- 534,00 7
- 317,00 7
- 305,00 7
- 490,00 7
- 387,00 7
- 433,00 7
- 460,00 7
- 259,00 7
- 760,00 7
- 555,00 7
- 363,00 7
- 205,00 7
- 299,00 7
- 233,00 7
- 696,00 7
- 471,00 7
- 426,00 7
- 427,00 7
- 491,00 7
- 217,00 6
- 614,00 6
- 88,00 6
- 382,00 6
- 119,00 6
- 474,00 6
- 378,00 6
- 381,00 6
- 357,00 6
- 514,00 6
- 475,00 6
- 295,00 6
- 626,00 6
- 219,00 6
- 207,00 6
- 686,00 6
- 165,00 6
- 193,00 6
- 331,00 6
- 277,00 6
- 179,00 6
- 616,00 6
- 285,00 6
- 257,00 6
- 138,00 6
- 800,00 6
- 349,00 6
- 102,00 6
- 345,00 6
- 428,00 6
- 265,00 6
- 750,00 6
- 145,00 6
- 493,00 6
- 203,00 6
- 650,00 6
- 850,00 6
- 391,00 6
- 371,00 6
- 413,00 6
- 621,00 6
- 572,00 6
- 588,00 6
- 461,00 6
- 554,00 6
- 700,00 6
- 519,00 6
- 321,00 6
- 540,00 6
- 672,00 6
- 752,00 6
- 501,00 6
- 566,00 6
- 664,00 6
- 655,00 5
- 197,00 5
- 114,00 5
- 273,00 5
- 792,00 5
- 365,00 5
- 125,00 5
- 562,00 5
- 398,00 5
- 545,00 5
- 269,00 5
- 369,00 5
- 343,00 5
- 736,00 5
- 319,00 5
- 342,00 5
- 107,00 5
- 211,00 5
- 95,00 5
- 445,00 5
- 409,00 5
- 705,00 5
- 229,00 5
- 399,00 5
- 267,00 5
- 395,00 5
- 525,00 5
- 127,00 5
- 506,00 5
- 189,00 5
- 137,00 5
- 191,00 5
- 281,00 5
- 78,00 5
- 628,00 5
- 293,00 5
- 237,00 5
- 740,00 5
- 478,00 5
- 632,00 5
- 90,00 5
- 355,00 5
- 438,00 5
- 680,00 5
- 154,00 5
- 524,00 5
- 155,00 5
- 532,00 5
- 101,00 5
- 223,00 5
- 582,00 5
- 509,00 5
- 526,00 5
- 507,00 5
- 564,00 5
- 467,00 5
- 527,00 5
- 654,00 5
- 397,00 5
- 912,00 5
- 629,00 5
- 644,00 5
- 10000,00 5
- 481,00 5
Sayfa sayısı
- 160 46
- 200 44
- 176 42
- 240 42
- 192 39
- 208 38
- 288 37
- 224 36
- 280 36
- 320 36
- 120 33
- 184 32
- 232 31
- 400 31
- 168 30
- 144 29
- 230 29
- 304 28
- 296 28
- 128 28
- 384 27
- 272 27
- 336 27
- 416 27
- 136 27
- 248 27
- 264 26
- 112 26
- 178 25
- 216 25
- 352 25
- 312 25
- 360 25
- 300 25
- 256 24
- 202 24
- 166 24
- 220 24
- 152 23
- 142 23
- 368 23
- 134 23
- 238 22
- 210 22
- 302 22
- 174 22
- 206 22
- 194 22
- 464 21
- 212 21
- 262 21
- 344 20
- 244 20
- 150 20
- 448 20
- 235 19
- 270 19
- 204 19
- 282 19
- 314 19
- 246 19
- 260 19
- 266 19
- 278 18
- 292 18
- 198 18
- 268 18
- 472 18
- 214 18
- 392 18
- 209 17
- 158 17
- 218 17
- 236 17
- 376 17
- 310 17
- 170 17
- 96 17
- 480 17
- 234 17
- 328 17
- 186 17
- 512 17
- 138 16
- 284 16
- 132 16
- 126 16
- 190 16
- 250 16
- 164 16
- 110 16
- 196 16
- 228 16
- 148 16
- 294 16
- 326 16
- 223 16
- 366 16
- 252 15
- 456 15
- 124 15
- 188 15
- 116 15
- 408 15
- 274 15
- 286 15
- 340 15
- 306 15
- 258 14
- 318 14
- 528 14
- 239 14
- 290 14
- 440 14
- 254 14
- 242 14
- 199 14
- 162 14
- 222 14
- 380 14
- 140 14
- 432 14
- 183 14
- 424 13
- 201 13
- 195 13
- 146 13
- 358 13
- 364 13
- 156 13
- 104 13
- 334 13
- 454 13
- 414 13
- 226 13
- 203 13
- 249 13
- 127 12
- 350 12
- 362 12
- 227 12
- 133 12
- 90 12
- 253 12
- 147 12
- 640 12
- 122 12
- 182 12
- 600 12
- 372 12
- 143 12
- 80 12
- 180 12
- 338 12
- 324 11
- 301 11
- 189 11
- 172 11
- 375 11
- 135 11
- 255 11
- 98 11
- 213 11
- 322 11
- 173 11
- 130 11
- 1 11
- 402 11
- 316 11
- 247 11
- 305 11
- 374 11
- 219 11
- 365 11
- 420 11
- 205 11
- 291 11
- 139 11
- 431 11
- 308 11
- 251 11
- 102 11
- 388 11
- 332 11
- 518 11
- 154 11
- 303 11
- 131 11
- 412 11
- 261 10
- 215 10
- 92 10
- 576 10
- 175 10
- 470 10
- 544 10
- 404 10
- 390 10
- 155 10
- 398 10
- 241 10
- 330 10
- 468 10
- 462 10
- 542 10
- 356 10
- 84 10
- 153 10
- 496 10
- 560 10
- 185 10
- 157 10
- 386 10
- 137 10
- 592 10
- 444 10
- 118 9
- 78 9
- 275 9
- 129 9
- 522 9
- 267 9
- 276 9
- 568 9
- 370 9
- 413 9
- 64 9
- 399 9
- 187 9
- 445 9
- 396 9
- 357 9
- 271 9
- 534 9
- 179 9
- 371 9
- 159 9
- 237 9
- 486 9
- 506 9
- 442 9
- 161 8
- 181 8
- 550 8
- 95 8
- 106 8
- 499 8
- 307 8
- 536 8
- 654 8
- 342 8
- 339 8
- 119 8
- 503 8
- 125 8
- 171 8
- 105 8
- 348 8
- 594 8
- 191 8
- 245 8
- 309 8
- 163 8
- 217 8
- 466 8
- 346 8
- 197 8
- 406 8
- 114 8
- 243 8
- 492 8
- 321 8
- 315 7
- 169 7
- 616 7
- 410 7
- 229 7
- 584 7
- 341 7
- 476 7
- 167 7
- 662 7
- 319 7
- 436 7
- 87 7
- 101 7
- 193 7
- 393 7
- 233 7
- 333 7
- 439 7
- 488 7
- 588 7
- 428 7
- 211 7
- 566 7
- 500 7
- 354 7
- 108 7
- 337 7
- 478 7
- 526 7
- 455 7
- 363 7
- 269 7
- 558 7
- 297 7
- 415 7
- 552 7
- 498 7
- 151 7
- 100 7
- 530 7
- 490 7
- 696 7
- 516 7
- 378 6
- 221 6
- 510 6
- 367 6
- 86 6
- 504 6
- 347 6
- 298 6
- 149 6
- 382 6
- 313 6
- 768 6
- 121 6
- 293 6
- 141 6
- 287 6
- 508 6
- 433 6
- 165 6
- 474 6
- 520 6
- 385 6
- 99 6
- 231 6
- 417 6
- 225 6
- 437 6
- 680 6
- 88 6
- 494 6
- 394 6
- 403 6
- 263 6
- 257 6
- 632 6
- 111 6
- 103 6
- 638 6
- 395 6
- 452 6
- 277 6
- 349 6
- 281 6
- 107 6
- 471 6
- 289 6
- 407 5
- 564 5
- 438 5
- 295 5
- 493 5
- 335 5
- 484 5
- 453 5
- 259 5
- 113 5
- 422 5
- 207 5
- 648 5
- 379 5
- 93 5
- 279 5
- 608 5
- 482 5
- 720 5
- 614 5
- 391 5
- 460 5
- 554 5
- 325 5
- 351 5
- 426 5
- 624 5
- 664 5
- 123 5
- 509 5
- 446 5
- 389 5
- 323 5
- 535 5
- 655 5
- 425 5
- 477 5
- 672 5
- 401 5
- 596 5
- 688 5
- 355 4
- 656 4
- 650 4
- 427 4
- 381 4
- 553 4
- 63 4
- 590 4
- 273 4
- 485 4
- 599 4
- 299 4
- 525 4
- 780 4
- 800 4
- 682 4
- 712 4
- 311 4
- 79 4
- 620 4
- 397 4
- 285 4
- 331 4
- 82 4
- 580 4
- 538 4
- 383 4
- 283 4
- 555 4
- 678 4
- 343 4
- 524 4
- 556 4
- 450 4
- 527 4
- 513 4
Categories
- Çocuk Kitapları (17209)
- Hobi (1304)
- Edebiyat (39354)
- Genel Konular (8814)
- Sanat (2164)
- Tarih (8564)
- Politika Siyaset (6029)
- İslam (9447)
- Felsefe (3610)
- Müzik (559)
- Eğitim (5735)
- Akademik (5826)
- Sosyoloji (2605)
- İnsan ve Toplum (5295)
- Ekonomi (3545)
- Hukuk (2703)
- İnanç Kitapları - Mitolojiler (1168)
- Bilim - Mühendislik (1570)
- Psikoloji (1472)
- Yabancı Dilde Kitaplar (2240)
- Sağlık (1399)
- Periyodik Yayınlar (2054)
- Gezi ve Rehber Kitapları (835)
- Yemek Kitapları (357)
- Bilgisayar (558)
- Genel (0)
- Güncellenecek (0)
- GÜNCELLENECEK (0)
- Kırtasiye (0)
- Hizmet (7)
- Oyun - Oyuncak (0)
- Electronics (9)
- Apparel (10)
- Digital downloads (3)
- Books (3)
- Jewelry (3)
- Gift Cards (3)
Yayınevi
Akademik
İletişimin Sosyo - Politiği
26,60 TL
Etkili Öğretim Yöntemleri
Araştırma Temelli Uygulama Effective Teaching Methods - Research Based Practice
47,74 TL
Osmanlı Aile Hukuku
Gelenek ve Modern Arasında Hukuk-ı Aile Kararnamesi ve Sadreddin Efendi'nin Eleştirileri
15,60 TL
Customer service
Copyright © 2026 Your store name. All rights reserved.
Powered by nopCommerce